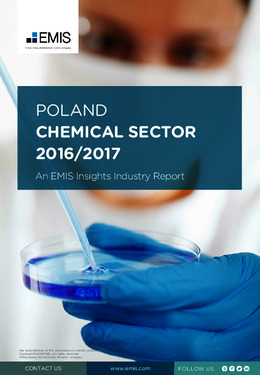
Poland Chemical Sector Report 2016/2017 - Page 1

Poland Chemical Sector Report 2016/2017
An EMIS Insights Industry ReportEMIS is an ISI Markets Company Date: November 2016
Pages: 74
Available in: English
The Polish chemical industry represents around 4% of the value of the European chemical market according to MarketLine data for 2015, which covers specialty chemicals, commodity chemicals, agricultural chemicals and pharmaceutical chemicals. The Polish market has significant potential for further growth. The share of the chemical sector in total manufacturing is 2% compared with an average 24% for Europe. The value-added output of Poland's broad market of fuels, chemicals, rubbers and plastics was 0.53% of the global output, according to estimates of Oxford Economics.
This report provides a complete and detailed analysis of the chemical sector for Poland. EMIS Insights presents in-depth business intelligence in a standard format across countries and regions, providing a balanced mix between analysis and data.
What this report allows you to do:
- Understand the key elements at play in the chemical sector in Poland
- Access forecasts for growth in the sector
- View key data on production and sales for the sector in Poland.
- Crystallise the forces both driving and restraining this sector in Poland
- Ascertain Poland’s position in the global sector
- Build a complete perspective on sector trade, investment and employment
- Understand the competitive landscape and who the major players are
- View M&A activity and major deals
- Gain an understanding of the regulatory environment for the sector in Poland.
- Build a clear picture of trends and issues for sub-sectors (e.g. chemicals and chemical products, rubber and plastic products).
See below for a complete table of report contents:
Email us at: emisstoresupport@isimarkets.com